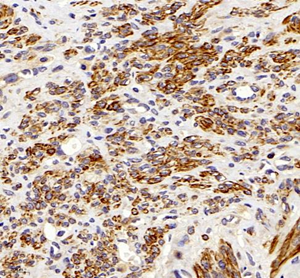

Anti-TIE2 Rabbit pAb
- 100 μL
Product Information
Description | TIE2 rabbit polyclonal antibody |
Protein full name | Angiopoietin-1 receptor |
Synonyms | TIE2, TIE-2, VMCM,VMCM1, CD202b,TEK Tyrosine Kinase, Endothelial, Tie2 |
Immunogen | KLH conjugated Synthetic peptide corresponding to Mouse Tie2 |
Isotype | IgG |
Purity | Affinity purification |
Subcellular location | Cell membrane, Cytoplasm, Secreted |
Uniprot ID | Q02763, Q02858 |
Applications
Applications | Species | Dilution | Positive Sample |
IHC/IF | Human, Mouse, Rat | 1:200-1:800 | endometrioma, liver, lung, thymus |
Background
The encoded protein possesses a unique extracellular region that contains two immunoglobulin-like domains, three epidermal growth factor (EGF)-like domains and three fibronectin type III repeats. The ligand angiopoietin-1 binds to this receptor and mediates a signaling pathway that functions in embryonic vascular development. Mutations in this gene are associated with inherited venous malformations of the skin and mucous membranes. Alternative splicing results in multiple transcript variants.
Images
|
Immunohistochemistry of paraffin embedded human endometrioma using TIE2 (GB11301) at dilution of 1:200 (400x lens) |
| Immunohistochemistry of paraffin embedded human liver using TIE2 (GB11301) at dilution of 1:200 (400x lens) |
| Immunohistochemistry of paraffin embedded mouse lung using TIE2 (GB11301) at dilution of 1:200 (400x lens) |
| Immunohistochemistry of paraffin embedded rat lung using TIE2 (GB11301) at dilution of 1:200 (400x lens) |
| Immunofluorescence of paraffin embedded mouse liver using TIE2 (GB11301) at dilution of 1:200 (400x lens) |
| Immunofluorescence of paraffin embedded mouse lung using TIE2 (GB11301) at dilution of 1:200 (400x lens) |
|
Immunofluorescence of paraffin embedded mouse thymus using TIE2 (GB11301) at dilution of 1:200 (400x lens) |
|
Immunofluorescence of paraffin embedded rat liver using TIE2 (GB11301) at dilution of 1:200 (400x lens) |
Storage
| Storage | Store at -20 ℃ for one year. Avoid repeated freeze/ thaw cycles. |
| Storage Buffer | PBS with 0.02% sodium azide, 100 μg/ml BSA and 50% glycerol. |
NOTE:
1.This product is intended for research only.
2.This product is recommended to dilute with the Primary Antibody Dilution Buffer (G2025).
| 货号 | 名称 | 规格 | 价格 | 操作 |
|---|
| 货号 | 名称 | 规格 | 价格 | 操作 |
|---|